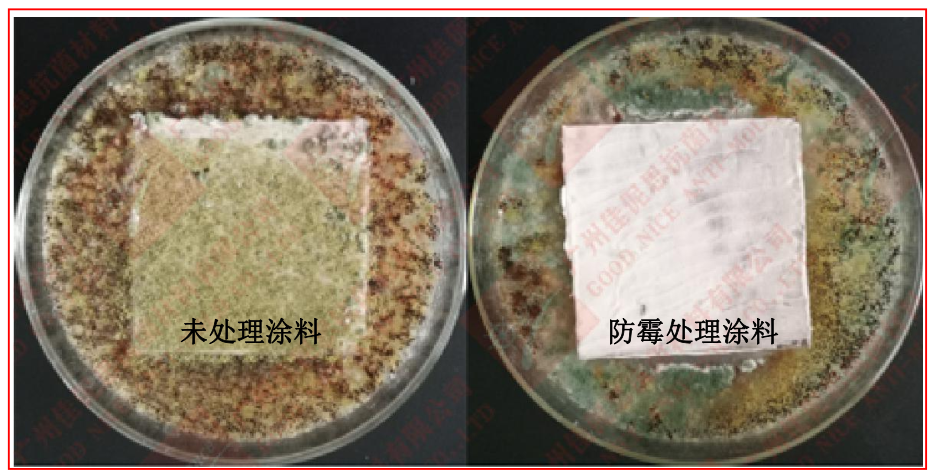
1676879998209.png image.png

概述
涂料防霉剂 AEM5700-T50 可用于涂料的防霉处理。涂料因其使用环境,如墙壁等容易发霉,需要进行防霉处理。 AEM5700-T50 可使添加后的涂料具有长效防霉作用,保护墙壁即使在潮湿环境下亦不发霉。
1.广谱防霉性:具有非常广泛的抗菌谱,对多种霉菌都具明显抗菌效果(见表 1);
2.防霉效率高:经 AEM5700-T50 处理的涂料,防霉等级可以达到 0 级;
3.效果持久,可长期对涂料及涂料覆盖范围进行防霉保护;
4.产品高效,添加量少;
5.良好的相容性和分散性,不改变涂料原有加工工艺,不改变涂料原有品质;
6.经过 Reach、Rohs 等相关环保认证。

适用范围
◎涂料
使用方法
本产品直接添加,使用量为 0.8%-1%,先少量添加混合均匀后,再大量添加,以下为一种添加的工业流程图:

2.添加后,一定要混合均匀,尽量一周内使用完。
3.产品打开后,如不使用,请密封好保存。
温馨提示
1.均匀加入,使用后请洗手;
2.初次使用请根据产品的颜色、透明度、相容性等质量要求以及是否符合加工工艺进行测试。
使用效果
-
环保木材防霉剂
点击收藏 查看详情 -
油漆防霉抗菌剂
点击收藏 查看详情 -
防霉喷剂
点击收藏 查看详情 -
纺织防霉抗菌剂
点击收藏 查看详情 -
皮革防霉抗菌剂
点击收藏 查看详情 -
涂料防霉剂(分散体)
点击收藏 查看详情






